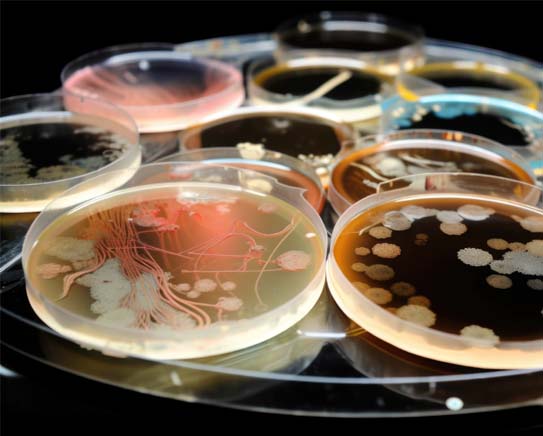

Opening Hours
| Monday-Friday | 08:00 am - 05:00 pm |
| Saturday & Sunday | Closed |
Quick Contact
For any question regarding Testing, please contact us:

CristoclearAnalytics
New Mexico's newest, state of the art lab, Cristoclear Analytics will provide the required state licensed certifications of analysis (COA)’s for the cannabis industry.
- “Safe cannabis production requires compliance & conformance to state regulations in order to ensure public health”
- “ Helping the consumer understand the use and application of cannabis products is in the infancy stage”
- “Further industry regulation and testing requirements are expected to increase”
Mission Statement
At Cristo Clear Analytics, we are committed to delivering precise results and data, driven by the integrity of our professionals and our unwavering dedication to excellence and continuous improvement. We pride ourselves on employing highly trained analysts who adhere to rigorous processes and procedures, ensuring the highest standards of quality and safety in every test we conduct. Our commitment to innovation and improvement propels us to continually enhance our methodologies, providing the public with a level of safety they can trust.
"Precision in every test. Integrity in every result."